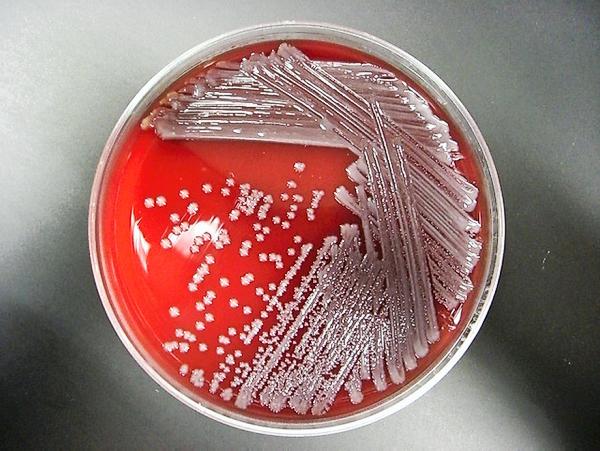

Part one, published last week, examined the role of antibiotics and antibiotic resistance. Part II looks at the use of antibiotics.
THE European Medicines Agency (EMA) is the EU organisation tasked with medicines availability and usage across the EU member states. They published a report in October 2014 which revealed EU antibiotic use in animals reduced by 15% between 2010 and 2012.


This is a subscriber-only article
It looks like you're browsing in private mode

SHARING OPTIONS: